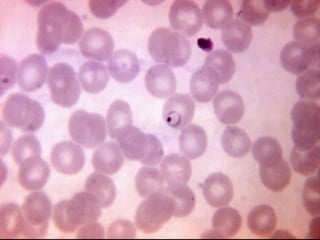
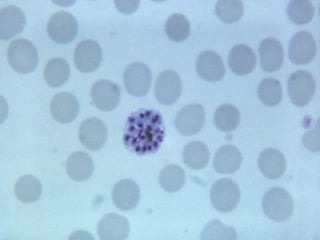
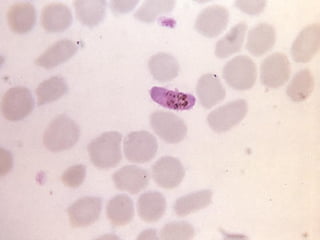

El documento proporciona información sobre parásitos intestinales. Explica que los parásitos incluyen protozoos como amebas y flagelados, así como helmintos como cestodos, trematodos y nematodos. Describe los mecanismos de transmisión, factores que inciden en la difusión, diagnóstico e implicaciones para la salud de diferentes parásitos.